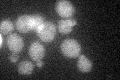
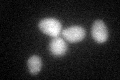
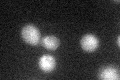
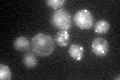

View description
Serine/threonine protein kinase involved in regulation of exocytosis; localizes to the cytoplasmic face of the plasma membrane; closely related to Kin2p
Localization:
Intensity:
Fold change:
Significance:
-
C’ GFP library in SD
cytosol24.89 -
N' NOP1pr-GFP in SD

cytosol66.5978 -
N' TEF2pr-mCherry in SD

cytosolN/A -
N' NATIVEpr-GFP in SD

cytosol30.0668 -
N' TEF2pr-VC and Cyto-VN in SD

cytosol46.2967 -
C’ GFP library in SD+DTT
cytosol28.861.15No -
C’ GFP library in SD+H2O2
cytosol29.461.18No -
C’ GFP library in Starvation Media
punctateN/AN/AYes -
C’ GFP library on the background of Pup2-DaMP

cytosol -
C’ GFP library on the background of CCT mutant

cytosol18.82240.756059No
